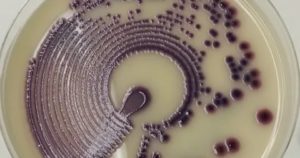

Дисбактериоз, Citrobacter freundii
Цитробактер, citrobacter (freundii, spp): что это, виды, патогенность, лечение — ЛОР ОНЛАЙН

Citrobacter – палочковидные бактерии, которые относятся к классу гамма-протеобактерий. Являются условно-патогенными представителями и составляющими нормальной микрофлоры.
В процессе своей жизнедеятельности микроорганизмы перерабатывают цитраты и применяют компоненты для своего пропитания. По структуре схожи с сальмонеллами. Бактерия способна присутствовать в почве, воде и каловых массах людей и животных. Основной способ передачи – фекально-оральный.
Заражение может быть осуществлено при употреблении некачественных пищевых продуктов. Инфекционная патология протекает остро. Микроорганизмы преимущественно поражают толстый кишечник, провоцируют нарушение функционирования желудка и кишечного тракта.
Группа микроорганизмов включает несколько видов, в том числе и Citrobacter freundii. Все микроорганизмы имеют отличительные особенности.
Цитробактер является компонентом нормальной кишечной микрофлоры
Общая информация о бактерии
Цитробактер фреунди и иные виды патологии могут быть обнаружены во всех отделах толстого кишечника. Микроорганизмы способны выходить за пределы органа и тем самым провоцировать развитие разнообразных патологий ЖКТ, мочеполовой системы, желчного пузыря и т.д.
Наиболее активно совершают свою деятельность микроорганизмы при наличии в организме новорожденного малыша. Признаки бактерии дадут о себе знать уже спустя 3 часа.
Цитробактер – часто встречающаяся первопричина болезней мочевыводящих путей и ангиогенных инфекций. Периодически наблюдаются вспышки заболеваемости в различных образовательных и дошкольных учреждениях.
Наибольшую опасность цитробактер представляет для организма новорожденных
Располагаются микроорганизмы одиночно или парами. Достаточно подвижны и устойчивы ко многим антибактериальным препаратам. Диагностировать инфекцию можно только при помощи комплексного исследования.Снизить заболеваемость можно путем употребления высококачественных пищевых продуктов. При приобретении пищи важно удостовериться в наличии сертификата качества. При подозрении на наличие патологии требуется срочно обратиться в медицинское учреждение.
Виды микроорганизмов
Род цитробактер включает разные виды бактерий. Всего врачи насчитывают 11 представителей. Их возможно обнаружить в:
- почве;
- воде;
- пищевых продуктах и многих иных объектах окружающей среды.
Ряд представителей рода цитробактер очень опасны для здоровья человека
Большинство из представителей рода бактерий не являются патогенными. Иные представлены в таблице.
| Citrobacter freundii, Citrobacter koseni, | Энтерит, уретрит, холецистит, отит и поражения дыхательных органов. |
| Citrobacter diversus | Менингит и абсцесс головного мозга |
Перечисленные бактерии относятся к патогенным. Пациенту требуется как можно скорее посетить медицинское учреждение. При отсутствии лечения высок риск стремительного ухудшения состояния и возникновения осложнений.
Еще один патогенный микроорганизм – Citrobacter spp. Бактерия является возбудителем многих внутрибольничных инфекций. Устойчив почти ко всем антибактериальным препаратам. Эффективное лечение может подобрать только врач. Делать это самостоятельно не рекомендуется.
Цитробактер может присутствовать в почве
Цитробактер диверсус – один из наиболее опасных представителей рода. Микроорганизм является причиной болезней, которые провоцируют большое количество необратимых осложнений. В некоторых случаях могут привести к инвалидности. Возникают нарушения ЦНС. На запущенной стадии возможна смерть.
Первопричины возникновения инфекции
Основные переносчики инфекции – животные и люди. Присутствующий цитробактер в анализе кала попадает в дальнейшем в почву или воду вместе с испражнениями. Каловые массы, оказавшиеся в условиях окружающей среды, становятся источником заражения. Происходит инфицирование иных людей или животных.
Каждый должен знать, что за инфекция цитробактер. Будучи осведомленным в причинах заражения, можно существенно снизить риск возможного инфицирования.
Основной путь заражения – фекально-оральный
Чаще всего микроорганизмы попадают в организм вместе с:
- молоком и молочными продуктами;
- кондитерскими изделиями;
- мясом курицы;
- говядиной, свининой и иными типами мяса.
Citrobacter freundii у грудничка в кале или детей более старшего возраста может появиться при взаимодействии с предметами ухода и игрушками. Заражение происходит при значительном ослаблении иммунной системы.
Путь передачи заболевания фекально-оральный. Цитробактер у грудничка возникает по вине родителей, которые не следят за личной гигиеной малыша и недостаточно обрабатывают игрушки и иные бытовые предметы. Микроорганизмы представляют огромную опасность для новорожденных детей.
Патология также может быть следствием контактирования с зараженным грунтом. Организм будет с большой вероятностью инфицирован при недостаточной гигиене рук. Помимо этого, врачи не рекомендуют употреблять грязные овощи и фрукты.
Инфицирование может произойти в результате употребления в пищу недостаточно обработанных продуктов животноводства
К чему может привести инфекция
Citrobacter amalonaticus и иные представители рода бактерий чаще всего приводят к поражению мочевыводящих, желчных и дыхательных путей. Высок риск возникновения внутрибольничных антигенных инфекций.
Патология приводит к развитию:
- гастроэнтерита;
- менингита;
- токсикоинфекции;
- абсцессу головного мозга;
- урологическим заболеваниям;
- гнойниковых инфекций;
- сепсиса.
Citrobacter frendii в кале – это серьезное нарушение. При отсутствии лечения патология способна обернуться летальным исходом, так как некоторые осложнения необратимы.
Заражение цитробактером может привести к развитию менингита
В последнее время зафиксировано большое количество случаев возникновения инфекции у целых групп детей, посещающих дошкольное учреждение или школу. Это обусловлено несоблюдением санитарных норм и технологий по приготовлению пищи.
Симптоматика нарушения
Цитробактер в анализе кала у грудничка или взрослого редко присутствует бессимптомно. Клиническая картина зависит от вреда, который нанесли микроорганизмы микрофлоре и всему здоровью в целом. К общим проявлениям относят:
- снижение аппетита;
- упадок сил;
- стремительное снижение массы тела;
- признаки недостатка витаминов;
- малокровие;
- расстройство стула с посторонними примесями;
- вздутие живота;
- повышенное газообразование;
- увеличение температуры тела до 39 градусов;
- болевой синдром в желудке.
У пациента может присутствовать как один симптом, так и все сразу. Выраженная интенсивность признаков присутствует не более 6 часов. Затем состояние незначительно улучшается.
Отсутствие аппетита – один из признаков заражения цитробактером
Симптоматика у детей отличается от проявления патологии у взрослых. У ребенка присутствует:
- увеличение температуры до 40 градусов;
- сильные позывы к рвоте;
- раздражительность;
- апатия;
- вялость;
- потеря интереса к окружающим факторам;
- жидкий стул с прожилками крови;
- кожные высыпания, сопровождающиеся зудящим ощущением.
Наиболее тяжело протекает заболевание у детей до года. При возникновении симптоматики малыш нуждается в срочной госпитализации. Игнорировать присутствующие признаки опасно, так как состояние может обернуться летальным исходом.
В более старшем возрасте патология протекает менее интенсивно. Однако ребенок также нуждается в помощи медицинских работников. При наличии цитробактер дети становятся вялыми и отказываются от игр и еды.
У ребенка постоянно присутствует тошнота. Вес малыша стремительно снижается из-за отказа от еды. Он начинает отставать в физическом развитии от своих сверстников и ощущает хронический упадок сил.
https://www.youtube.com/watch?v=UQExR7nTO-k
Анализ кала – один из методов диагностики патологии
Диагностические методы
При микробиологическом обследовании фекальных масс цитробактер рассматривают комплексно с иными условно-патогенными бактериями, которых относят к семейству энтеробактерий. В норме количество бактерий на 1 г кала не должно превышать 10*4. При большем содержании следует заподозрить присутствие какого-либо нарушения.
Помимо этого пациенту могут дать направление на:
- анализ крови;
- УЗИ;
- эндоскопию.
Набор диагностических мер зависит от возраста пациента и запущенности состояния. Лечение цитробактер фреунди и иных подвидов патологии осуществляется только после комплексного исследования.
О кишечных инфекциях и их последствиях для здоровья рассказывается в видео:
Лечение нарушения
Медикаментозное лечение предусматривает прием пробиотиков. Помимо этого, пациенту может рекомендоваться антибактериальная терапия. Подбор препаратов осуществляется врачом. Лечение цитробактер направлено на восстановлении кишечной микрофлоры. Пациенту могут порекомендовать:
- Амикацин;
- Цефтазидим;
- Азлоциллин.
Избавиться от патологии будет нетрудно, если нарушение было обнаружено своевременно. Больному рекомендуют соблюдать диету. Исключают из рациона:
- жареное;
- пряное;
- жирное и продукты, способные спровоцировать брожение.
Требуется добавить в повседневный рацион как можно больше фруктов, зелени, овощей и кисломолочных продуктов.
Мнение эксперта
Цитробактер может стать причиной серьезных патологий кишечника и желудка, при превышении допустимых показателей, он нарушает всасывание полезных элементов, что негативно сказывается на состоянии, особенно у детей первого года жизни.
По этой причине лечить заболевание нужно. Но важно учесть, что цитробактер крайне устойчив к антибактериальным препаратам, а его лечение обязательно должно включать средства на основе интерферонов.
Обязательными также будут препараты для нормализации микрофлоры (пробиотики и пребиотики).
Источник:
Цитробактер в кале: нужно ли лечить инфекцию?
Цитробактер (в бланках результатов лабораторного исследования кала обозначается как C. amalonaticus, C. freundii, C. koseri) – относится к группе условно-патогенных бактерий, которые населяют кишечник и каловые массы человека.
При адекватном функционировании иммунной системы не опасен для здоровья и жизни. О заболевании, вызываемом цитробактером, можно говорить только в ситуации, когда снижен иммунитет, а количество нормальных представителей кишечной микрофлоры существенно ниже нормы.
Разновидности микроорганизма
В организме здорового человека могут быть обнаружены несколько видов цитробактера. Например:
- Citrobacter koseri (цитробактер козери);
- Citrobacter freundii (цитробактер фреунди);
- Citrobacter diverticus (цитробактер диверсус);
- Citrobacter brakiii (цитробактер браакии);
- Citrobacter amalonaticus (цитробактер амалонатикус).
Практической значимости в описании различных типов цитробактера нет.
Любой вид цитробактера обнаруживается в кишечнике здорового человека, что не является признаком патологии и основанием для постановки диагноза. Реже эта бактерия высевается из мочеполовых путей.
Источник: https://dikulug.ru/infektsii/tsitrobakter-citrobacter-freundii-spp-chto-eto-vidy-patogennost-lechenie.html
Цитробактер в кале: нужно ли лечить инфекцию?

Цитробактер (в бланках результатов лабораторного исследования кала обозначается как C. amalonaticus, C. freundii, C. koseri) – относится к группе условно-патогенных бактерий, которые населяют кишечник и каловые массы человека.
При адекватном функционировании иммунной системы не опасен для здоровья и жизни.
О заболевании, вызываемом цитробактером, можно говорить только в ситуации, когда снижен иммунитет, а количество нормальных представителей кишечной микрофлоры существенно ниже нормы.
Чем опасен возбудитель?
В здоровом человеческом организме существует несколько десятков представителей так называемой условно-патогенной флоры.
Эти микроорганизмы способствуют поддержанию баланса в органах, так как занимают определенную площадь и не оставляют свободного места для колонизации патогенным микробам.
Как только их количество значительно уменьшается, возникает риск проникновения и размножения возбудителей инфекционных болезней. Именно поэтому нецелесообразно и даже небезопасно уничтожать условно-патогенную микрофлору.
Цитробактер может стать опасной для человека бактерией, только в условиях иммунодефицита. Снижение функциональных возможностей иммунной системы может быть врожденным (генетический дефект) или приобретенным. В этом случае цитробактер начинает активно размножаться, выделять в кровь токсические продукты жизнедеятельности, заселять не только поверхность слизистой кишечника, но и другие полости.
Оппортунистическая инфекция, вызванная цитробактером, может проявляться в таких клинических формах:
- менингит и менингоэнцефалит;
- воспаление дыхательных путей;
- поражение мочеполового тракта;
- общее заражение крови (сепсис).
Особенную опасность тяжелая оппортунистическая инфекция, вызванная цитробактером, представляет для детей первых 3-х лет жизни. При отсутствии адекватной терапии и позднем обращении за медицинской помощью такой процесс может закончится смертью ребенка.
Пути передачи и рост бактерии
О путях передачи цитробактера говорить не совсем правильно, так как этот микроорганизм постоянно находится внутри кишечника и проникновение нового пула не приводит к развитию заболевания.
Заселение кишечника разнообразными микроорганизмами начинается в первые часы жизни.
Это происходит при общении с окружающими людьми, использовании предметов обихода (посуда, игрушки, средства гигиены), а также в процессе грудного вскармливания.
Наибольшую опасность представляет так называемый искусственный (он же артифициальный) путь передачи. Для организма в состоянии иммунодефицита цитробактер становится внутрибольничной инфекцией. Его источником является медицинский персонал. Передача осуществляется при таких ситуациях:
- непосредственный контакт с медицинским персоналом;
- использование медицинского инструментария многоразового использования;
- выполнение различных медицинских манипуляций (инъекции, интубация и прочее).
Для человека с сохранной иммунной системой нет смысла опасаться попадания цитробактера в организм, избежать инфицирования практически невозможно. Росту и размножению бактерий способствует именно состояние иммунодефицита. Не существует каких-либо специальных ограничений для ограничения размножения этой бактерии.
Нормы содержания в кале
Цитробактер в испражнениях человека может обнаруживаться или не обнаруживаться.
- Отрицательный ответ – цитробактер не выявлен – означает, что этой бактерии в организме человека нет. В некоторых случаях такой ответ является результатом недостаточно тщательной работы лабораторного сотрудника, который проводил обследование.
- Положительный ответ – цитробактер обнаружен в кале человека – обычно указывается не только факт выявления, но и количество клеток. Этот показатель имеет диагностическую ценность в сочетании с клиникой.
Лечение
Лечение человеку, у которого выявлен цитробактер, назначается только в том случае, если есть жалобы и симптомы поражения ЖКТ.
Если человек отмечает кишечную дисфункцию, может быть, это и есть возможная причина нарушений.
Если какого-либо дискомфорта со стороны пищеварительного канала нет, то обнаружение цитробактера диагностической ценности не имеет и основанием для назначения терапии не является.Специфическая терапия в настоящее время не разработана. В комплексе лечебных мероприятий применяются:
- антибиотики с преимущественным воздействием на грамотрицательную микробную флору (метронидазол, тетрациклины);
- пробиотики и пребиотики;
- витаминные комплексы;
- панкреатические ферменты для улучшения процессов переваривания.
Решение о назначении терапии принимает доктор по результатам осмотра и комплексного обследования.
Прогноз
Благоприятный, если речь идет о кишечной дисфункции. Оппортунистическая инфекция, вызванная цитробактером, может привести к смерти больного, если он поздно обратился за медицинской помощью.
Профилактика
Целесообразно говорить не о профилактике цитробактерной инфекции, а о том, что необходимо делать для сохранения баланса нормальной микрофлоры кишечника. Большинству людей следует:
- уменьшить количество полуфабрикатов, консервантов, усилителей вкуса и прочего;
- соблюдать водный баланс;
- регулярно употреблять сезонные овощи и фрукты, а также молочные продукты.
Цитробактер – это, как правило, случайная находка при проведении комплексного обследования человека. Не представляет серьезной опасности и очень редко требует лекарственного вмешательства.
Источник: https://ProKishechnik.info/zabolevaniya/citrobakter.html
Цитробактер
Цитробактер – это грамотрицательные палочковидные бактерии, факультативные анаэробы, передвигающиеся при помощи жгутиков.
Свое название они получили от способности расщеплять соли лимонной кислоты (цитраты) для дальнейшего использования их в качестве источника углерода.
Бактерии обитают в кишечнике человека, являясь представителями условно-патогенной микрофлоры. Но даже минимальное увеличение их количества приводит к цитробактериозу.
Под микроскопом эти бактерии выглядят как небольшие палочки.
Микроорганизмы относятся к роду Citrobacter, входящему в состав семейства Enterobacteriaceae. На данный момент выявлено 11 видов, 3 из которых обладают патогенностью. К ним относятся:
- Citrobacter freundii, поражающие ЖКТ, желчные протоки, мочеполовую систему и органы дыхания;
- Citrobacter koseri и amalonaticus, провоцирующие энтерит, отит, воспаление желчного пузыря и уретры;
- Citrobacter diversus, вызывающие гнойное воспаление головного мозга и его оболочек.
Citrobacter spp. представляет собой бактерию в форме подвижной палочки. Она способна жить и размножаться как в анаэробной среде, так и в присутствии кислорода. Бактерия не образует спор и капсул, что делает ее малоустойчивой к негативным условиям внешней среды.
Видоспецифическим свойством цитробактер является выделение зловонного запаха при росте колоний на питательных средах.
Факторы патогенности микроорганизмов:
- наличие поверхностного белка, обеспечивающего прикрепление к окружающим объектам;
- способность продуцировать эндо- и энтеротоксины;
- выделение колицина;
- наличие перитрихиально расположенных ворсинок;
- устойчивость к антибиотикам.
Представители Citrobacter обнаруживаются в каловых массах, почве и сточных водах. При фекально-оральном или контактном способе заражения они проникают в желудочно-кишечный тракт человека. Благодаря хорошей адгезии бактерии взаимодействуют с рецепторами, проникают внутрь эпителиальных клеток, где размножаются и продуцируют токсины, вызывая нарушение пищеварительной функции.
В случае усиленного размножения микробы распространяются на другие органы и системы, провоцируя у человека:
- уретрит и цистит;
- отит;
- воспалительные процессы в мозге и мозговых оболочках;
- остеомиелит;
- воспаление органов дыхания;
- поражение гепатобилиарной системы;
- сепсис.
Часто цитробактеры становятся причиной внутрибольничных инфекций.
Виды цитробактера и их опасность для человека
Опасными для человеческого здоровья являются только 4 вида бактерий.
Citrobacter koseri и Citrobacter amalonaticus вызывают классические проявления инфекционного энтерита, поражают желчные протоки, мочевыводящие пути, становятся причиной дисфункции дыхания.
Citrobacter freundii любит жить в эпителиальных клетках толстого кишечника, но способен проникать в другие системы организма, вызывая их патологии. Данные бактерии являются наиболее опасными для детского здоровья штаммами, так как проявляют свою патогенность уже через 2 часа с момента проникновения. При своевременно начатом правильном лечении наступает быстрое выздоровление в 100% случаев.
Citrobacter diversus является возбудителем менингитов с частыми осложнениями, приводящими к инвалидности или летальному исходу.
Поражение мозговых оболочек в первый месяц жизни ребенка провоцирует гнойные абсцессы, лечение которых проводится хирургическим путем в комплексе с антибиотикотерапией.
Помимо нервной системы, цитробактер диверсус проникает в дыхательные пути и сердце, вызывая в них воспаление.
Другие виды Citrobacter могут длительное время присутствовать в организме человека, не обнаруживая себя, а также могут персистировать (постоянно находиться) у некоторых млекопитающих, насекомых и рыб.
Взрослый человек чаще всего заражается фекально-оральным и пищевым путем при употреблении кондитерских изделий, мясных, молочных продуктов и сливочного масла, выпущенных с нарушением гигиены и технологии производства.
Для детей более характерен контактно-бытовой путь заражения кишечными инфекциями через игрушки, предметы ухода и немытые руки. У грудничков инфицирование может произойти из-за несоблюдения родителями правил санитарии, а также введения в рацион малыша некачественного прикорма.
Но основным переносчиком возбудителя является больной человек. С калом и зараженными рвотными массами больного бактерии попадают в почву и сточные воды, распространяясь и поражая других людей.
Диагностика возбудителя цитробактериоза
Окончательный диагноз может поставить только специалист после сбора анамнеза, клинического осмотра, получения данных лабораторных исследований на наличие в биоматериале бактерий цитробактер. В некоторых случаях требуется дополнительное УЗИ внутренних органов и эндоскопия желудка.
Анализ кала
Обнаружение в анализе кала цитробактер, концентрация которого составляет 10 в 5 или 6 степени, указывает на дисбактериоз, требующий лечения. Исключение составляют случаи, когда у пациента регистрируются заболевания, связанные с иммунодефицитом, так как организм не способен самостоятельно удерживать развитие бактерий.
Иногда увеличение количества Citrobacter freundii в кале может указывать на пролиферацию тканей кишечника, являющуюся признаком рака.
Норма цитробактер фреунди в кале ребенка в возрасте до 1 года составляет менее 104 микробных тел в 1 г кала. Характерно, что в этот период они обитают в тонком кишечнике.
Диагностика не ограничивается количественным определением в кале ребенка Citrobacter freundii. Параллельно проводится выявление других патогенных микроорганизмов, которые всегда сопутствуют цитробактериозу.
Анализ мочи
Для подтверждения диагноза обязательным считается количественное определение цитробактер в моче у ребенка. На данный показатель большое влияние оказывает нарушение техники забора материала и условий его транспортировки. Поэтому порцию утренней мочи необходимо отбирать в стерильную емкость и сразу же доставлять ее в лабораторию.
Вагинальный мазок
Наличие бактерий Citrobacter diversus в мазке у женщин свидетельствует о неправильном заборе материала. Это происходит, когда представители условно-патогенной микрофлоры кишечника попадают в исследуемый материал из анального отверстия.
Мазок из зева и носа
При взятии мазков из носа и зева для обнаружения цитробактера используют стерильные ватные палочки. Данная манипуляция проводится до приема пищи. При этом специалист следит за тем, чтобы инструмент не соприкасался с поверхностью языка и другими органами ротовой полости.
Как протекает цитробактериоз
Симптоматика цитробактериоза достаточно разнообразна и обусловлена следующими факторами:
- возраст пациента;
- уровень иммунитета;
- индивидуальная чувствительность к факторам патогенности бактерий;
- проводилась ли ранее антибиотикотерапия;
- вид бактерии.
Общие признаки разных заболеваний, вызванных Citrobacter:
- быстрая утомляемость, даже без физических и эмоциональных нагрузок;
- снижение аппетита;
- анемичность видимых слизистых оболочек;
- резкая потеря веса.
Гастроэнтерит
Заболевание начинает развиваться с болей в области солнечного сплетения. При надавливании болезненность ощущается также в области тонкого кишечника.
Другие клинические признаки:
- температурные колебания находятся в промежутке между 37.3 и 38.8°С;
- тошнота со рвотой;
- жидкий стул, кратность которого в сутки превышает 9-10 раз;
- при колите в кале присутствуют прожилки свернувшейся крови, гноя и тяжей слизи.
Цитробактер может провоцировать спазм мускулатуры толстого отдела кишечника, проявляющегося вздутием, непроходимостью каловых масс и запорами.
У грудничков Citrobacter вызывает молниеносное повышение температуры до 40°С, сопровождающееся рвотой. Если ребенок очень резко становится вялым, перестает реагировать на слова и прикосновения, то требуется срочная госпитализация.
Характерный признак болезни — это жидкий кал зеленого цвета с тяжами слизи, сменяемый обильными водянистыми испражнениями.
Поражение дыхательных путей
Первое время цитробактериоз практически сразу проявляется резким температурным скачком до показателей свыше 40°С, вялостью, болью в горле и груди. При осмотре и рентгеноскопии у пациентов обнаруживаются бронхиты, ларингиты и пневмония.
Цистит, уретрит
У грудничков-девочек Citrobacter koseri может спровоцировать воспаление мочеполовой системы при нерегулярной и несвоевременной смене подгузников, когда кишечная микрофлора проникает в мочевыводящий канал или влагалище.
У взрослых поражение органов данной системы может стать следствием заноса инфекции во время осмотра или хирургических манипуляций.
Другие проявления
Цитробактериоз может сопровождаться аллергическими реакциями – зудом, высыпаниями на кожных покровах и слизистых. У новорожденных младенцев в течение суток могут развиться септические явления.
Но наибольшую опасность представляют менингиты и мозговые абсцессы. Они вызывают необратимые процессы, влекущие за собой инвалидность и смерть.
Лечение цитробактера у детей и взрослых
Вылечить такое заболевание, как цитробактериоз, можно, применяя комплексную терапию, включающую в себя:
- антибактериальные препараты;
- симптоматические средства;
- пероральную регидратацию, чтобы снять интоксикацию и предотвратить обезвоживание;
- пробиотики и ферментные препараты, восстанавливающие кишечную микрофлору и нормализующие процесс пищеварения;
- витаминные и минеральные комплексы.
В настоящее время ученые выделили 4 природных бактериофага, поражающих цитробактер. Однако они еще мало изучены и не применяются для лечения людей и животных.
Прежде чем лечить заболевания, вызванные цитробактер, необходимо дифференцировать их от патологий, спровоцированных морганеллами. Они имеют схожую симптоматику.
Для лечения цитробактер фреунди особенно эффективен левофлоксацин. На бактерии цитробактер также хорошо воздействуют такие препараты, как Нифуроксазид, Ципрофлоксацин, Фуразолидон, некоторые аминогликозиды и цефалоспорины.
Для восстановления пищеварительной системы назначаются:
- Бифидумбактерин;
- Линекс;
- Лактобактерин;
- Фестал;
- Хилак;
- Панкреатин и другие ферментные средства и пробиотики.
В обязательном порядке назначается диетотерапия. Из рациона больного исключаются:
- кондитерские изделия и выпечка;
- острые, жареные и соленые блюда;
- продукты, содержащие большое количество жиров;
- алкоголь;
- сырые овощи и фрукты.
Первое время меню состоит из слизистых каш и супов-пюре. Постепенно в рацион вводятся кисломолочные продукты, паровые котлеты из диетических сортов мяса, яичные белки.
Питание должно быть дробным, не менее 5-6 раз в течение дня.
Citrobacter у животных
Животные являются носителями бактерий и источниками заражения людей. При этом проявления заболеваний у них нет. В редких случаях у кроликов цитробактер имеет вид персистирующей патологии, проявляющейся энтеритом.
Избежать заражения человеку помогает правильная термическая обработка продуктов животного происхождения и соблюдение условий их хранения.
Источник: https://probakterii.ru
Источник: http://doctorbifi.ru/publ/lechenie_probiotikamy/disbakterioz_kishechnika/citrobakter/5-1-0-232
Цитробактер: что это за инфекция, почему появляется в анализе, как лечить

Цитробактер – это грамотрицательные палочковидные бактерии, факультативные анаэробы, передвигающиеся при помощи жгутиков.
Свое название они получили от способности расщеплять соли лимонной кислоты (цитраты) для дальнейшего использования их в качестве источника углерода.
Бактерии обитают в кишечнике человека, являясь представителями условно-патогенной микрофлоры. Но даже минимальное увеличение их количества приводит к цитробактериозу.
Под микроскопом эти бактерии выглядят как небольшие палочки
Всё про бактерию: свойства, таксономия, строение, жизненный цикл, патогенность
Микроорганизмы относятся к роду Citrobacter, входящему в состав семейства Enterobacteriaceae. На данный момент выявлено 11 видов, 3 из которых обладают патогенностью. К ним относятся:
- Citrobacter freundii, поражающие ЖКТ, желчные протоки, мочеполовую систему и органы дыхания;
- Citrobacter koseri и amalonaticus, провоцирующие энтерит, отит, воспаление желчного пузыря и уретры;
- Citrobacter diversus, вызывающие гнойное воспаление головного мозга и его оболочек.
Citrobacter spp. представляет собой бактерию в форме подвижной палочки. Она способна жить и размножаться как в анаэробной среде, так и в присутствии кислорода. Бактерия не образует спор и капсул, что делает ее малоустойчивой к негативным условиям внешней среды.
Видоспецифическим свойством цитробактер является выделение зловонного запаха при росте колоний на питательных средах.
Факторы патогенности микроорганизмов:
- наличие поверхностного белка, обеспечивающего прикрепление к окружающим объектам;
- способность продуцировать эндо- и энтеротоксины;
- выделение колицина;
- наличие перитрихиально расположенных ворсинок;
- устойчивость к антибиотикам.
Представители Citrobacter обнаруживаются в каловых массах, почве и сточных водах. При фекально-оральном или контактном способе заражения они проникают в желудочно-кишечный тракт человека. Благодаря хорошей адгезии бактерии взаимодействуют с рецепторами, проникают внутрь эпителиальных клеток, где размножаются и продуцируют токсины, вызывая нарушение пищеварительной функции.
В случае усиленного размножения микробы распространяются на другие органы и системы, провоцируя у человека:
- уретрит и цистит;
- отит;
- воспалительные процессы в мозге и мозговых оболочках;
- остеомиелит;
- воспаление органов дыхания;
- поражение гепатобилиарной системы;
- сепсис.
Часто цитробактеры становятся причиной внутрибольничных инфекций.
Виды цитробактера и их опасность для человека
Опасными для человеческого здоровья являются только 4 вида бактерий.
- Citrobacter koseri и Citrobacter amalonaticus вызывают классические проявления инфекционного энтерита, поражают желчные протоки, мочевыводящие пути, становятся причиной дисфункции дыхания.
- Citrobacter freundii любит жить в эпителиальных клетках толстого кишечника, но способен проникать в другие системы организма, вызывая их патологии. Данные бактерии являются наиболее опасными для детского здоровья штаммами, так как проявляют свою патогенность уже через 2 часа с момента проникновения. При своевременно начатом правильном лечении наступает быстрое выздоровление в 100% случаев.
- Citrobacter diversus является возбудителем менингитов с частыми осложнениями, приводящими к инвалидности или летальному исходу. Поражение мозговых оболочек в первый месяц жизни ребенка провоцирует гнойные абсцессы, лечение которых проводится хирургическим путем в комплексе с антибиотикотерапией. Помимо нервной системы, цитробактер диверсус проникает в дыхательные пути и сердце, вызывая в них воспаление.
Другие виды Citrobacter могут длительное время присутствовать в организме человека, не обнаруживая себя, а также могут персистировать (постоянно находиться) у некоторых млекопитающих, насекомых и рыб.
Из-за чего начинается болезнь
Взрослый человек чаще всего заражается фекально-оральным и пищевым путем при употреблении кондитерских изделий, мясных, молочных продуктов и сливочного масла, выпущенных с нарушением гигиены и технологии производства.
Для детей более характерен контактно-бытовой путь заражения кишечными инфекциями через игрушки, предметы ухода и немытые руки. У грудничков инфицирование может произойти из-за несоблюдения родителями правил санитарии, а также введения в рацион малыша некачественного прикорма.
Но основным переносчиком возбудителя является больной человек. С калом и зараженными рвотными массами больного бактерии попадают в почву и сточные воды, распространяясь и поражая других людей.
Диагностика возбудителя цитробактериоза
Окончательный диагноз может поставить только специалист после сбора анамнеза, клинического осмотра, получения данных лабораторных исследований на наличие в биоматериале бактерий цитробактер. В некоторых случаях требуется дополнительное УЗИ внутренних органов и эндоскопия желудка.
Анализ кала
Обнаружение в анализе кала цитробактер, концентрация которого составляет 10 в 5 или 6 степени, указывает на дисбактериоз, требующий лечения. Исключение составляют случаи, когда у пациента регистрируются заболевания, связанные с иммунодефицитом, так как организм не способен самостоятельно удерживать развитие бактерий.
Иногда увеличение количества Citrobacter freundii в кале может указывать на пролиферацию тканей кишечника, являющуюся признаком рака.
Норма цитробактер фреунди в кале ребенка в возрасте до 1 года составляет менее 104 микробных тел в 1 г кала. Характерно, что в этот период они обитают в тонком кишечнике.
Диагностика не ограничивается количественным определением в кале ребенка Citrobacter freundii. Параллельно проводится выявление других патогенных микроорганизмов, которые всегда сопутствуют цитробактериозу.
Анализ мочи
Для подтверждения диагноза обязательным считается количественное определение цитробактер в моче у ребенка. На данный показатель большое влияние оказывает нарушение техники забора материала и условий его транспортировки. Поэтому порцию утренней мочи необходимо отбирать в стерильную емкость и сразу же доставлять ее в лабораторию.
Анализ на Citrobacter выполняется только для свежесобранной мочи
Вагинальный мазок
Наличие бактерий Citrobacter diversus в мазке у женщин свидетельствует о неправильном заборе материала. Это происходит, когда представители условно-патогенной микрофлоры кишечника попадают в исследуемый материал из анального отверстия.
Мазок из зева и носа
При взятии мазков из носа и зева для обнаружения цитробактера используют стерильные ватные палочки. Данная манипуляция проводится до приема пищи. При этом специалист следит за тем, чтобы инструмент не соприкасался с поверхностью языка и другими органами ротовой полости.
Как протекает цитробактериоз
Симптоматика цитробактериоза достаточно разнообразна и обусловлена следующими факторами:
- возраст пациента;
- уровень иммунитета;
- индивидуальная чувствительность к факторам патогенности бактерий;
- проводилась ли ранее антибиотикотерапия;
- вид бактерии.
Общие признаки разных заболеваний, вызванных Citrobacter:
- быстрая утомляемость, даже без физических и эмоциональных нагрузок;
- снижение аппетита;
- анемичность видимых слизистых оболочек;
- резкая потеря веса.
Гастроэнтерит
Заболевание начинает развиваться с болей в области солнечного сплетения. При надавливании болезненность ощущается также в области тонкого кишечника.
Другие клинические признаки:
- температурные колебания находятся в промежутке между 37.3 и 38.8°С;
- тошнота со рвотой;
- жидкий стул, кратность которого в сутки превышает 9-10 раз;
- при колите в кале присутствуют прожилки свернувшейся крови, гноя и тяжей слизи.
Цитробактер может провоцировать спазм мускулатуры толстого отдела кишечника, проявляющегося вздутием, непроходимостью каловых масс и запорами.
У грудничков Citrobacter вызывает молниеносное повышение температуры до 40°С, сопровождающееся рвотой. Если ребенок очень резко становится вялым, перестает реагировать на слова и прикосновения, то требуется срочная госпитализация.
Характерный признак болезни — это жидкий кал зеленого цвета с тяжами слизи, сменяемый обильными водянистыми испражнениями.
Поражение дыхательных путей
Первое время цитробактериоз практически сразу проявляется резким температурным скачком до показателей свыше 40°С, вялостью, болью в горле и груди. При осмотре и рентгеноскопии у пациентов обнаруживаются бронхиты, ларингиты и пневмония.
Цистит, уретрит
У грудничков-девочек Citrobacter koseri может спровоцировать воспаление мочеполовой системы при нерегулярной и несвоевременной смене подгузников, когда кишечная микрофлора проникает в мочевыводящий канал или влагалище.
У взрослых поражение органов данной системы может стать следствием заноса инфекции во время осмотра или хирургических манипуляций.
Другие проявления
Цитробактериоз может сопровождаться аллергическими реакциями – зудом, высыпаниями на кожных покровах и слизистых. У новорожденных младенцев в течение суток могут развиться септические явления.
Но наибольшую опасность представляют менингиты и мозговые абсцессы. Они вызывают необратимые процессы, влекущие за собой инвалидность и смерть.
Лечение цитробактера у детей и взрослых
Вылечить такое заболевание, как цитробактериоз, можно, применяя комплексную терапию, включающую в себя:
- антибактериальные препараты;
- симптоматические средства;
- пероральную регидратацию, чтобы снять интоксикацию и предотвратить обезвоживание;
- пробиотики и ферментные препараты, восстанавливающие кишечную микрофлору и нормализующие процесс пищеварения;
- витаминные и минеральные комплексы.
В настоящее время ученые выделили 4 природных бактериофага, поражающих цитробактер. Однако они еще мало изучены и не применяются для лечения людей и животных.
Прежде чем лечить заболевания, вызванные цитробактер, необходимо дифференцировать их от патологий, спровоцированных морганеллами. Они имеют схожую симптоматику.
Для лечения цитробактер фреунди особенно эффективен левофлоксацин. На бактерии цитробактер также хорошо воздействуют такие препараты, как Нифуроксазид, Ципрофлоксацин, Фуразолидон, некоторые аминогликозиды и цефалоспорины.
Для восстановления пищеварительной системы назначаются:
- Бифидумбактерин;
- Линекс;
- Лактобактерин;
- Фестал;
- Хилак;
- Панкреатин и другие ферментные средства и пробиотики.
В обязательном порядке назначается диетотерапия. Из рациона больного исключаются:
- кондитерские изделия и выпечка;
- острые, жареные и соленые блюда;
- продукты, содержащие большое количество жиров;
- алкоголь;
- сырые овощи и фрукты.
Первое время меню состоит из слизистых каш и супов-пюре. Постепенно в рацион вводятся кисломолочные продукты, паровые котлеты из диетических сортов мяса, яичные белки.
Питание должно быть дробным, не менее 5-6 раз в течение дня.
Citrobacter у животных
Животные являются носителями бактерий и источниками заражения людей. При этом проявления заболеваний у них нет. В редких случаях у кроликов цитробактер имеет вид персистирующей патологии, проявляющейся энтеритом.
Среди всех животных – носителей бактерии только у кроликов иногда отмечаются проявления цитробактериоза
Избежать заражения человеку помогает правильная термическая обработка продуктов животного происхождения и соблюдение условий их хранения.
Работаю врачом ветеринарной медицины. Увлекаюсь бальными танцами, спортом и йогой. В приоритет ставлю личностное развитие и освоение духовных практик. Любимые темы: ветеринария, биология, строительство, ремонт, путешествия. Табу: юриспруденция, политика, IT-технологии и компьютерные игры.
Источник: https://probakterii.ru/prokaryotes/species/citrobacter.html
